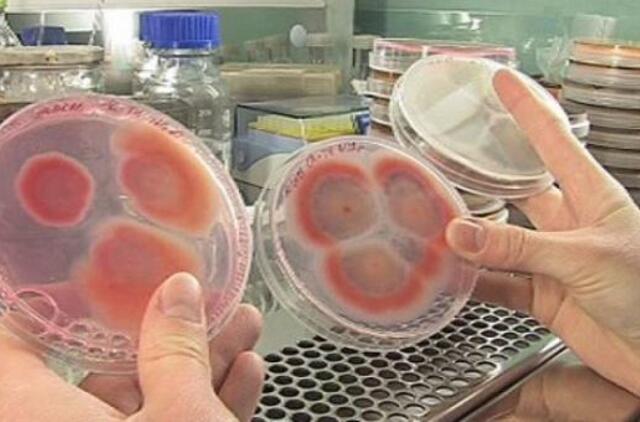
Biojutikliai: netrukus arklienos jautienoje ieškosime patys

Padeda medicinoje ir maisto pramonėje
Maisto pramonę krečia skandalai: Europoje į jautieną kažkas pridėjo pigesnės arklienos, Kinijoje į mėsos gaminius ne vienerius metus sukčiai įmaišydavo žiurkienos. Globaliame pasaulyje maisto kokybės kontrolė tampa gyvybiškai svarbi, siekiant išvengti masinių apsinuodijimų ar epidemijų. Biojutikliais galima greitai ir patikimai demaskuoti tokius atvejus, nustatyti įvairiomis pavojingomis bakterijomis užkrėstus vaisius ir atlikti kitus panašius veiksmus.
Biojutikliai – labai maži, bet gudrūs prietaisai, padedantys žmonėms registruoti įvairiausių – ypač kenksmingų– medžiagų koncentraciją ore, skysčiuose ir kitur. Štai kodėl jie taip paplito medicinoje bei maisto pramonėje, o jų paklausa nemažėja.
„Jutikliai – labai svarbu. Jie skirti matuoti medžiagos kiekį. Maisto ar medicinos pramonėje galima nustatyti produkto koncentraciją. Tarkime, kai tam tikra medžiaga kaupiasi organizme dėl ligos arba maiste, kai jis genda ar gamintojai į jį prideda, ko nereikėtų“, – aiškina chemikė Dr. Rasa Pauliukaitė.
Aflatoksinas, salmonelės, botritis, listerijos, ochratoksinas, E.coli bakterijų štamai – tai tik keli pavojingų mikroorganizmų ar toksinų pavadinimai, kurie aptinkami ant įvairių vaisių, mėsos produktuose ir kitur. Biojutikliai idealiai tinka maisto pramonėje, nes jie specifiški, veikia selektyviaI ir greitai. Jais tiksliai nustatomas pesticidų kiekis produktuose, matuojami gliukozės, sacharozės, alkoholio koncentracijų pokyčiai, kurie yra svarbus ir nedviprasmiškas maisto kokybės įvertinimas.
Renkasi naujoves
Lietuvoje net kelios mokslininkų grupės kuria tokius prietaisus. Tarp jų – dr. Rasos Pauliukaitės komanda iš fizinių ir technologijos mokslų centro. Kuo šie jutikliai skiriasi nuo įprastinių?
„Pasirinkome naują, nevisiškai ištyrinėtą medžiagą – grafeną. Buvo įdomu ją panaudoti šioje srityje. Be to, naudojame lazerines technologijas, kurios jutiklių srityje dar retai diegiamos. Norime sujungti kuo daugiau technologijų ir disciplinų“, – savo jutiklių išskirtines savybes vardijo chemikė.
Rezultatas – iškart
Jutikliai dažniausiai būna akustiniai, temperatūriniai, piezoelektriniai, optiniai arba elektrocheminiai. Pastaruoju metu jutikliai tampa vis mažesni. Jie pradedami gaminti iš nanodalelių ar nanovamzdelių. Negana to, siekiant kuo greičiau demaskuoti pavojingus ligų sukėlėjus ant papajų, augančių plantacijose kur nors Malaizijoje, mokslininkai montuoja jutiklius prie augalų ir sujungia juos į bevielį tinklą. Tokiu būdu galima realiu laiku kontroliuoti laukuose bręstančių kavos pupelių ar vynuogių būklę. Dar viena tendencija – sumanios pakuotės (angl. intelligent packaging). Juose integruoti biojutikliai suteIkia informaciją apie transportuojamo maisto kokybę, apie vietos, kur jis laikomas, mikroklimatą.
„Dirbame su paprastesniais – elektrocheminiais – jutikliais, atsakymą gauname labai greitai, nereikia ruošti pavyzdžio. Tai maži daikčiukai, kuriuos panarinus į skystį iš karto paaiškėja, kiek jame yra ieškomos medžiagos“, – pasakoja R. Pauliukaitė.
Jutiklis sudarytas iš kelių dalių. Elektrodas gali būti bet kokia laidi medžiaga, turinti kontaktą su potenciostatu. Pasirinkimas priklauso nuo to, ką norime nustatyti, nes jutikliams tinka ne visi elektrodai. Pavyzdžiui, elektrodams naudojant auksą, platiną arba grafitą, jais nustatoma daug skirtingų medžiagų vienu metu, todėl signalai užgožia vienas kitą. Ką daryti?
„Kad jutiklis būtų tikras, jis modifikuojamas: padengiamas cheminiais junginiais, kurie atpažįsta norimą objektą ar junginį, su juo sureaguoja. Reakcijos metu gaunami elektronai patenka į elektrodą ir potenciostate gauname signalą. Mūsų darbas – gauti medžiagas, kurios gerai atpažintų mūsų norimą objektą“, – kalba chemikė.
Maisto kokybės kontrolė
Mokslininkai ES struktūrinių fondų finansuojamame projekte „Nano ir lazerinių technologijų panaudojimas grafeno tyrimui ir modifikavimui bei biojutiklių, skirtų maisto kokybės kontrolei, konstravimui ir miniatiūrizavimui“ savo taikiniu pasirinko keletą medžiagų, kurias svarbu kuo anksčiau aptikti maisto produktuose.
„Kadangi mūsų projektas yra skirtas maisto kokybės nustatymui, dirbame su askorbo rūgšties ir su gliukozės jutikliais. Taip pat kuriame jutiklius, kurie fiksuos baltymą putresciną, atsirandantį gendant maistui“, – atskleidė Rasa Pauliukaitė.
Tyrėjai ketina pagaminti degtukų dėžutės dydžio prietaisą, iš kurio kyšos elektrodas. Užlašinus tiriamo skysčio lašą, bus galima greitai nustatyti ieškomos medžiagos koncentraciją. Panašūs jutikliai konstruojami ir kitose laboratorijose. Maisto kokybei nustatyti iki šiol dažniausiai būdavo naudojami optiniai jutikliai. Deja, mėginio paruošimas analizei užtrukdavo vieną ar net kelias dienas. Tuo tarpu elektrocheminiai jutikliai veikia kur kas operatyviau. Siekiant pagerinti jutiklių jautrumą, naudojamos nanotechnologijos.
„Naudojant makrotechnologijas, nustatyti galima tik gana dideles koncentracijas. Naudojant nanotechnologijas, fiksuojamos paviršinės reakcijos ir nustatomos žymiai mažesnės koncentracijos. Nanotechnologijose viskas yra greta, todėl reakcijos vyksta žymiai greičiau ir paprasčiau“, – dėstė Dr. Rasa Pauliukaitė.
Pasitelkė lazerius
Kadangi Lietuvoje tradiciškai stiprus lazerių mokslas, biojutiklių kūrėjai nusprendė pasinaudoti kolegų sukurtomis technologijomis.
„Sugalvojome nanotechnologijų gamybai panaudoti lazerius: su lazeriu struktūrizuoti jutiklio paviršių, kad į tam tikras elektrodo „saleles“ būtų lengviau susodinti cheminius elementus“, – aiškino chemikė.
Lazerines technologijas kuria mokslininkai viename skyriuje, o nanostruktūrų gamyba vyksta greta esančioje laboratorijoje. Čia pluša biologai, chemikai, fizikai, ieškodami atpažinimo molekulių, kurios geriausiai tiktų biojutikliams.
„Atpažinimo molekulės dažniausiai yra fermentai, kurie perdirba norimą molekulę. Geriausias pavyzdys – gliukozė. Pramonėje naudojama gliukozės dehidrogenazė, o mes naudojame gliukozės oksidazę. Gliukozės oksidazės atveju susidaro vandenilio peroksidas. Elektrochemiškai jį lengva nustatyti, nes greitai redukuojasi ar oksiduojasi“, – subtilybes aiškina chemikė.
Mokslininkai parenka fermentus, kuriems reaguojant į tiriamą medžiagą, išsiskiria vandenilio peroksidas. Mokslininkai taip pat ieško elektrai laidžių polimerų, kurie naudojami įvairiose kitose srityse. Pasirodo, kad jie irgi puikiai tinka biojutikliams. Pavyzdžiui, jie reaguoja į citrinų ar askorbo rūgštį.
„Elektrochemija patogi tuo, kad galima nustatyti tam tikrą intervalą, kuriame vyksta reakcija. Pakeitus intervalą, nustatomas jau kitas junginys“, – atkreipia dėmesį mokslininkė.
Laikysime šaldytuvuose
Kadangi dirbama su biologinėmis molekulėmis, jas stabilizuoti ant elektrodo paviršiaus, kad jos kuo ilgiau išliktų aktyvios, nelengva. Fermentai yra gana gležni, jautrūs aplinkos pokyčiams. Vaizdžiai sakant, ant elektrodo jie surakinami, sukaustomi grandinėmis ir jų stabilumas sumažėja, todėl jutiklių kūrėjai prideda papildomų baltymų, pavyzdžiui, albumino, kuris padidina fermentų darbo efektyvumą.
„Jei biojutiklis gyvena dvi savaites, yra gerai. Tai, ką darome, yra vienkartiniai jutikliai. Mums reikia nanotechnologijų, nes dabar naudojami dideli brangiai kainuojantys fermentų kiekiai“, – dėsto chemikė.
Vienas miligramas tokio fermento gali kainuoti net tūkstantį eurų. Todėl svarbu ne tik sumažinti jo kiekį biojutiklyje, bet ir pailginti prietaiso naudojimo laiką. Kol jutikliai nenaudojami, jie laikomi šaldytuve. Kambario temperatūroje jie išlieka veiklūs maždaug dvi savaites.
Po kelerių metų kiekvienas iš mūsų galės kontroliuoti, ar ekologiškuose produktuose nėra kokių nors etiketėje nepažymėtų konservantų ar egzotiškų priemaišų. Tokių, kaip žiurkės mėsa ar arkliena.
„Jutikliai naudojami norint įsitikinti, ar kažko nėra papildomai pridėta, tik tai, kas užrašyta. Žmogus gali įsigyti prietaisą ir kol nenaudoja, jį laikyti šaldytuve“, – kalba R. Pauliukaitė.
Kol kas mokslininkai prisipažįsta nežinantys, ar paklausa bus pakankama. Patobulintus biojutiklius bus galima naudoti ir maisto pramonėje, ypač tarpiniuose maisto gamybos procesuose, nuolat tikrinant, ar išlaikomos nustatytos maisto produkto gamybos sąlygos.
„Pasirinkome jutiklius kancerogeninėms, pavojingoms sveikatai medžiagoms, taip pat toms, kurioms žmonės alergiški ir kurias verta nustatinėti. Pavyzdžiui, gliukozę, kurią ne visi toleruoja“, – vardijo mokslininkė.
Čia naudojama labai perspektyvi medžiaga – grafenas. Pasaulyje jis pastaruoju metu plinta greitai, kadangi turi daug privalumų ir tinka kuriant įvairius jutiklius. Tuo įsitikino ir Lietuvos tyrėjai, lazeriu apdorojantys biojutiklio paviršių taip, kad biocheminės reakcijos ant jo vyktų kuo sparčiau.
„Mūsų projektas baigsis 2015 metų pavasarį. Planuojame turėti kelis veikiančius biojutiklius (nebūtinai patį produktą, bet jo prototipą), sumažinti potenciostatą iki degtukų dėžutės dydžio ir turėti keletą tokių elektrodų, kurie nustatinėtų produktus“, – ateities planus vardijo chemikė Dr. Rasa Pauliukaitė.
Ne tik maisto pramonėje
Sugebėjimas greitai identifikuoti virusus ar bakterijas praverčia ne tik maisto pramonėje. Tokie prietaisai naudojami kovoje su terorizmu, vertinant vaistų saugumą bei kokybę, nustatant diagnozę pacientams. Visai neseniai Nacionalinėje Lawrence Livermore laboratorijoje JAV sukurtas biojutiklis, galintis nustatyti net 3000 skirtingų virusų ar bakterijų per 24 valandas. Tokie jautrūs bei universalūs instrumentai padidins maisto produktų saugumą, leis agronomams stebėti ant augalų įsitaisiusius patogenus arba greitai diagnozuoti ligą.
Matyt, gyvensime dar saugiau.

Rašyti komentarą